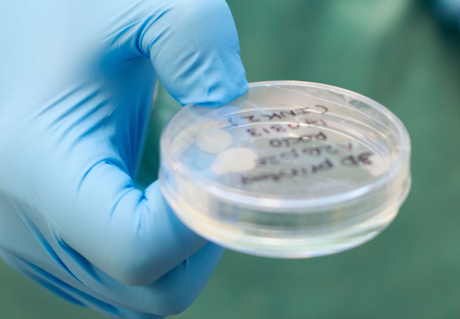

- Hem
- Aktuellt
- Hitta nyheter
- Framgång för 3D-printat brosk
Framgång för 3D-printat brosk
Ett forskarlag vid Sahlgrenska akademin har lyckats skapa broskvävnad genom att skriva ut stamceller med en 3D-printer. Att stamcellerna överlevde att skrivas ut på detta sätt är en framgång i sig. Dessutom kunde forskarlaget få cellerna att föröka sig och differentiera till brosk i den utskrivna strukturen.
Ett forskarlag vid Sahlgrenska akademin har lyckats skapa broskvävnad genom att skriva ut stamceller med en 3D-printer. Att stamcellerna överlevde att skrivas ut på detta sätt är en framgång i sig. Dessutom kunde forskarlaget få cellerna att föröka sig och differentiera till brosk i den utskrivna strukturen.
Resultaten publiceras i Nature-tidskriften Scientific Reports. Forskningen är gjord i samarbete med ett forskarlag vid Chalmers, som är experter på 3D-printning av biologiska material. Även forskare inom ortopedi i Kungsbacka ingår i forskningssamarbetet.
Forskarlaget har använt broskceller tagna från människor i samband med knäoperationer, och dessa celler har sedan backats tillbaka i sin utveckling i laboratoriet så att de återgått till att bli så kallade pluripotenta stamceller, alltså stamceller som har potential att utvecklas till många olika typer av celler. Stamcellerna har sedan omslutits i en struktur av nanocellulosa och skrivits ut till en struktur med 3D-printer. Efter utskriften har stamcellerna behandlats med tillväxtfaktorer för att differentiera dem rätt och bilda brosk.
Luras att tro att de inte är ensamma
Publiceringen i Scientific Reports är resultatet av tre års hårt arbete.
 – Differentieringen av stamceller till brosk fungerar enkelt i naturen, men är betydligt svårare i provrör. Vi är först med att lyckas med det, helt utan djurförsök, konstaterar Stina Simonsson, docent i cellbiologi, som lett forskarlagets arbete.
– Differentieringen av stamceller till brosk fungerar enkelt i naturen, men är betydligt svårare i provrör. Vi är först med att lyckas med det, helt utan djurförsök, konstaterar Stina Simonsson, docent i cellbiologi, som lett forskarlagets arbete.
Det stora arbetet har varit att hitta ett protokoll som fungerar, och som gör att cellerna differentierar på rätt sätt och bildar brosk.
– Vi har undersökt olika metoder och kombinerat olika tillväxtfaktorer. Varje enskild stamcell är inkapslad i nanocellulosa för att de ska överleva att skrivas ut till en 3D-struktur, och vi har tagit medium från andra celler som innehåller de signaler som stamceller använder för att kommunicera med varandra under differentieringsprocessen. Vår teori är att vi lyckats lura cellerna att tro att de inte är ensamma, för att uttrycka det enkelt, säger Stina Simonsson.
En viktig insikt som forskarlaget gjort genom studien är att det krävs stora mängder levande celler för att bilda vävnad på detta sätt.
Det brosk som bildas av stamcellerna i den 3D-utskrivna strukturen är mycket lik mänskligt brosk. Erfarna kirurger som hanterat det tillverkade brosket ser ingen skillnad mot riktigt brosk, och har framfört att materialet har egenskaper som liknar brosk de ser i patienter. Precis som vanligt brosk uttrycker det tillverkade materialet kollagen 2, och i mikroskop ser cellerna fina ut, med strukturer som liknar de som syns i bitar av brosk från människa.
Potentiell behandling vid artros
Studien innebär ett rejält steg framåt för möjligheten att kunna skapa kroppsegen, ny broskvävnad. I en inte alltför avlägsen framtid skulle vi kunna använda 3D-printer för att ta fram brosk baserat på egna, backade stamceller, för att laga broskskador, eller använda som en behandling vid artros, som innebär att brosk i leder degenereras och bryts ned. Artros är mycket vanligt – en av fyra svenskar över 45 år drabbas i någon grad.
I teorin ger forskningen förutsättningar för att kunna skapa stora mängder brosk, men det återstår en stor fråga som behöver lösas innan resultaten kan komma patienter till nytta:
– Den struktur av cellulosa vi använt är inte optimalt att använda i kroppen. Innan vi börjar undersöka möjligheten att använda 3D-printat brosk när patienter opereras, behöver vi hitta ett annat material, som kan brytas med av kroppen så att det bara är kroppseget brosk kvar, säger Stina Simonsson.
Länk till artikeln. Ansvarig forskare: Stina Simonsson.
 Foto: Elin Lindström Claessen
Foto: Elin Lindström Claessen